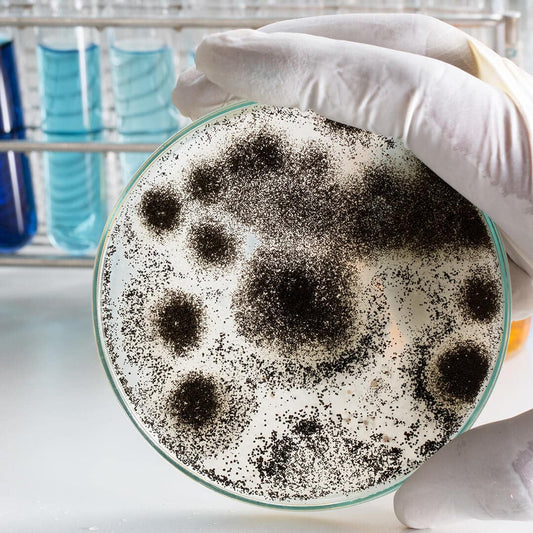

Mould in the bathroom
The Moisture Paradise
The only thing that mould needs to grow is moisture. Especially in the bathroom, where high humidity levels are regularly present, mould finds optimal conditions to spread. Here, a dehumidifier or fan can provide temporary relief. The bathroom is often referred to as a paradise for mould. Daily showering and bathing significantly increases humidity, which promotes the formation of condensation on walls and ceilings.